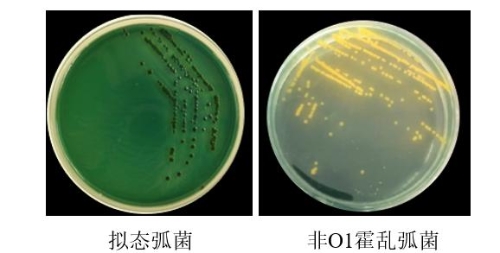

2020年1月3日,江苏现代农业(青虾)产业技术体系病害防控与质量控制创新团家张晓君教授带领团队成员前往兴化市开展青虾病害调研与技术指导,团队成员先后到泰州兴化千垛镇西坝村和海南镇东湖村两个村的多家青虾养殖场开展调研。张晓君教授通过与养殖户的交流,详细了解了该地区青虾的养殖模式、放养密度、喂养情况、水草种植种类以及病害发生情况等。在座谈的过程中了解到,7月份放入的虾苗在10月初开始出现散发性死亡现象,发病青虾鳃部有小红点,部分青虾尾扇发红,通过使用抗菌药物以及消毒剂后,红鳃症状得到缓解,初步怀疑为细菌引起的红鳃病。随后,病害团队成员现场采集发病青虾、水样以及底泥等样品,带回实验室进行后期分析。
通过实验室中平板划线,发病青虾携带大量单一细菌,将分离到的病原菌,经细菌纯化、革兰氏染色、生化鉴定以及16S rDNA分子鉴定,确认病原为非O1霍乱弧菌和拟态弧菌。非O1霍乱弧菌广泛分布在水环境中,是鱼类和无脊椎动物的重要病原菌,可感染罗氏沼虾、青虾、鲤鱼、泥鳅等水产动物,给水产养殖业造成了严重的经济损失。拟态弧菌与霍乱弧菌亲缘关系很近,最初认为是非典型生化特性的霍乱弧菌,其形态学、DNA序列及性质与霍乱弧菌极相似,但生化反应不典型,霍乱弧菌能分解多种糖,产酸不产气,拟态弧菌与霍乱弧菌最重要的区别是不发酵蔗糖。本实验室将分离的霍乱弧菌和拟态弧菌分别接种于TCBS培养基,发现霍乱弧菌菌落呈黄色,拟态弧菌菌落呈绿色。霍乱弧菌与拟态弧菌对青虾的半数致死浓度基本相同,表明其对青虾的致病力相同,感染拟态弧菌的青虾,其症状与霍乱弧菌感染相似,主要表现为躯体和附肢发红,本团队将深入研究拟态弧菌对青虾的致病机制及防控方法,以便对减少青虾红体病的发生提供理论基础。